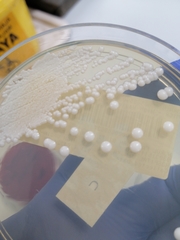
Candida albicans

Candida albicans: taxon details and analytics
- Domain
- Kingdom
- Fungi
- Phylum
- Ascomycota
- Class
- Saccharomycetes
- Order
- Saccharomycetales
- Family
- Saccharomycetaceae
- Genus
- Candida
- Species
- Candida albicans
- Scientific Name
- Candida albicans
Summary description from Wikipedia:
Candida albicans in languages:
- Czech
- kandida bělostná
- Swedish
- torsk
- Swedish
- muntorsk
Images from inaturalist.org observations:
We recommend you sign up for this excellent, free service.
Parent Taxon
Sibling Taxa
- Candida albicans
- Candida atakaporum
- Candida auris
- Candida glabrata
- Candida intermedia
- Candida kanchanaburiensis
- Candida maris
- Candida neustonensis
- Candida nongkhaiensis
- Candida oceani
- Candida parapsilosis
- Candida rongomai-pounamu
- Candida saitoana
- Candida sake
- Candida santamariae
- Candida spencermartinsiae
- Candida tropicalis
- Candida vespimorsuum
- Candida vini
- Candida zeylanoides